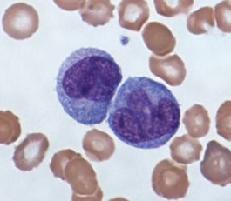
базофилы понижены

Базофилы — клетки крови, образование которых осуществляется в костном мозге, затем они выходят в кровь, циркулируя в ней несколько часов, и далее направляются в ткани, где пребывают на протяжении 8-12 суток.
Базофилы — клетки крови, образование которых осуществляется в костном мозге, затем они выходят в кровь, циркулируя в ней несколько часов, и далее направляются в ткани, где пребывают на протяжении 8-12 суток.
Это наиболее малочисленная лейкоцитарная группа, которая в основном участвует в аллергических реакциях немедленного типа.
Когда в крови базофилы понижены у взрослого, это говорит о наличие заболевания — базопения. Такое состояние могут диагностировать при содержании в периферической крови базофилов менее 0,01*109/л. Сделать конкретные выводы сразу бывает проблематично даже специалистам, однако зачастую речь идет об истощении лейкоцитарного запаса в организме.
Если базофилы понижены у взрослого, причины могут быть весьма различными, наиболее распространенные из них мы рассмотрим в этой статье
Роль базофилов в организме
Образование базофилов происходит в костном мозге, откуда они попадают в кровоток и циркулируют в нем в течение нескольких часов. Далее базофильные лейкоциты мигрируют в клеточные ткани, оставаясь там от 8 до 12 дней, где и выполняют свои основные функции.
Главная функция базофилов — вовремя обнаружить и подавить аллергены, не дать им распространиться по всему организму и призвать остальных гранулоцитов к месту воспаления.
Базофилы принимают прямое участие в реакциях аллергического типа. Кроме этого их можно встретить в тонких капиллярах, где они отвечают за кровоток. Несмотря на то, что одной из функций базофилов является фагоцитоз, их роль в укреплении иммунитета или защите организма крайне мала. Эти белые клетки принимают важное участие в процессе свёртываемости крови и способствуют увеличению проницаемости сосудов. Также они отвечают за сокращение некоторых групп мышц.
Норма
При заборе крови для общего анализа крови определение базофилов, как известно, входит в подсчет определенной лейкоцитарной формулы.
Таким образом, норма базофилов обозначена в следующих показателях:
- Новорожденные — 0,75%
- Дети в возрасте 1 месяца — 0,5%
- Годовалый ребенок — 0,6%
- Дети в возрасте 2 лет — 0,7%
- Взрослые — от 0,5 до 1%
Увеличение количества клеток базофилов (когда базофилы повышены в крови — более чем 0,2*109/л) называют базофилией. Уменьшение в периферической крови количества клеток базофилов (когда она понижены и анализ показывает менее чем 0,01*109/л) — называют базопенией.
Причины пониженных базофилов
Почему базофилы понижены у взрослого, о чем это говорит? Основными причинами, когда в крови диагностируются базофилы ниже нормы могут являться следующие патологические состояния:
- инфекционные болезни;
- стресс;
- беременность;
- болезнь Кушинга;
- гипертиреоз.
- при регулярных стрессовых состояниях;
- при аллергии с яркими проявлениями;
- при инфекционных заболеваниях;
- при активной работе щитовидной железы;
- при болезнях надпочечников;
- при пневмонии;
- при приеме некоторых гормональных препаратов.
Стоит отметить, что в период овуляции и беременности также могут наблюдаться эти показатели. Поэтому очень важно делать диагностику в комплексе. Стоит сказать, что и стрессовые ситуации могут значительно снизить содержание базофилов в периферической крови.

Что делать, если базофилы понижены
Как и в любом другом случае, прежде всего, следует искать первопричину данного явления. Если такое заболевание будет выявлено, основная терапия должна быть направлена на борьбу именно с ним, а после этого уровень базофилов придет к необходимой норме.
Если каких-то причин для повышения их уровня не оказалось, тогда возможно, что это произошло из-за общего ослабления иммунитета, а значит, все силы следует направить именно на его укрепление.

